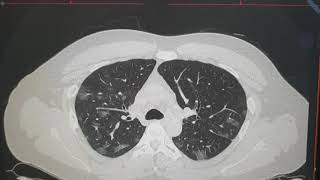

n Corona virus 2019 COVID CT features video
Online izle ve mp4 mp3 formatlarinda yukle

Videonun muddeti: 4:21
n Corona virus 2019 COVID CT features videosu mp4 ve mp3 yuklemek ucun hazirdir
Diqqet! Siz Mp4 yukle ve ya Mp3 yukle duymesine basdiqdan sonra eger sistem sizi reklam sehifesine atarsa o zaman derhal geri qayidib emeliyyati tekrar edin ve faylin yuklemek ucun hazir olmasini gozleyin
Videodan Mp4 Yukle
Videodan Mp3 Yukle-1
Videodan Mp3 Yukle-2
Oxshar Axtarishlar
 n Corona virus 2019- COVID CT features
n Corona virus 2019- COVID CT features Chest XR and CT in the Coronavirus Pandemic COVID19
Chest XR and CT in the Coronavirus Pandemic COVID19 Chest CT Findings in Coronavirus Disease-19 (COVID-19): Relationship to Duration of Infection
Chest CT Findings in Coronavirus Disease-19 (COVID-19): Relationship to Duration of Infection COVID-19 : Coronavirus Disease Radiology Imaging Features within 5 Minutes
COVID-19 : Coronavirus Disease Radiology Imaging Features within 5 Minutes Describing chest CT findings in COVID 19
Describing chest CT findings in COVID 19 COVID-19 (Coronavirus Disease 19) March Update- causes, symptoms, imaging features x-ray CT
COVID-19 (Coronavirus Disease 19) March Update- causes, symptoms, imaging features x-ray CT Coronavirus Epidemic Update 27: Testing accuracy for COVID-19 (CT Scan vs. RT-PCR), California Cases
Coronavirus Epidemic Update 27: Testing accuracy for COVID-19 (CT Scan vs. RT-PCR), California Cases COVID-19 (Coronavirus): Typical Chest CT-Scan findings on a COVID-19 infected patient
COVID-19 (Coronavirus): Typical Chest CT-Scan findings on a COVID-19 infected patient Covid Part 2: Corona on Chest Xray and CT
Covid Part 2: Corona on Chest Xray and CT
Video Mp4 Mp3Azwap.Biz
Azwap.Biz 2021-2023


 n Corona virus 2019- COVID CT features
n Corona virus 2019- COVID CT features Chest XR and CT in the Coronavirus Pandemic COVID19
Chest XR and CT in the Coronavirus Pandemic COVID19 Chest CT Findings in Coronavirus Disease-19 (COVID-19): Relationship to Duration of Infection
Chest CT Findings in Coronavirus Disease-19 (COVID-19): Relationship to Duration of Infection COVID-19 : Coronavirus Disease Radiology Imaging Features within 5 Minutes
COVID-19 : Coronavirus Disease Radiology Imaging Features within 5 Minutes Describing chest CT findings in COVID 19
Describing chest CT findings in COVID 19 COVID-19 (Coronavirus Disease 19) March Update- causes, symptoms, imaging features x-ray CT
COVID-19 (Coronavirus Disease 19) March Update- causes, symptoms, imaging features x-ray CT Coronavirus Epidemic Update 27: Testing accuracy for COVID-19 (CT Scan vs. RT-PCR), California Cases
Coronavirus Epidemic Update 27: Testing accuracy for COVID-19 (CT Scan vs. RT-PCR), California Cases COVID-19 (Coronavirus): Typical Chest CT-Scan findings on a COVID-19 infected patient
COVID-19 (Coronavirus): Typical Chest CT-Scan findings on a COVID-19 infected patient Covid Part 2: Corona on Chest Xray and CT
Covid Part 2: Corona on Chest Xray and CT